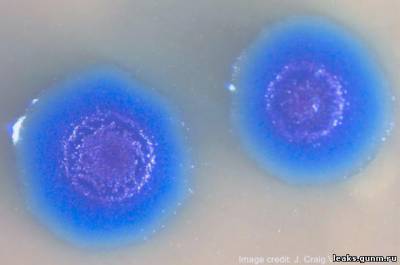

Синяя смерть от "British Petroleum"Детище «Синтетик Дженомикс Инкорпотэйтед» («Synthetic Genomics Inc.») создано по заказу Бритиш Петролеум якобы для борьбы с нефтяными разливами.
Эта новая форма жизни обладает свойством самовоспроизводиться и органически функционировать в любой клетке, в которую её внедрят.
Всё финансирование работ осуществлялось "Синтетик Дженомикс Инкорпотейтед" - компанией, с которой ВР состоит в альянсе и в которой имеет значительную долю активов.
При более внимательном рассмотрении оказалось, что речь может идти о случайном или преднамеренном создании и применении бактериологического оружия широкого спектра действия, представляющего потенциальную угрозу для жизни на Земле как таковой.
BP уже распылило в Мексикаснком заливе дисперсанты типа корексита с самолётов и морских судов - причем в состав этих дисперсантов были добавлены минеральные вещества с тем, чтобы бактерии могли более стремительно размножаться и быстрее поедать нефть. И этими бактериями-"поедателями" как раз и была "синтия".
Физические симптомы «ВР-гриппа», «ВР-слизи», «синего гриппа» - или как его ещё ни назови - столь же уникальны, как и синтетические бактерии, которые применяются в заливе. Поскольку человечество имеет в своей основе углерод, то как именно эти искусственно созданные и охочие до водорода и углерода бактерии будут воздействовать на плоть человека?
Внутренние кровотечения наряду с приводящими к изъязвлению поражениями кожи – вот типичные физические симптомы «почерка» созданной их компьютерами ДНК. На протяжении нескольких месяцев многие взрослые и дети, искупавшиеся или погулявшие у Залива, заболевают странной болезнью, от которой нет действенных средств. В коротких новостных сообщениях то и дело констатируется смерть жителей от т.н. "неизвестного вируса", "синего гриппа" или "синей чумы". И тишина... А ведь Мексиканский залив через Атлантику соединен со всем миром…
«В моей надувной лодке была вода, и когда я перевернула её, чтобы слить воду, я слегка поцарапалась; ранка была сантиметра 2 в длину и, может, миллиметр в ширину. Это произошло в 8 утра. К 4 часам дня область вокруг ранки начала болеть и воспалилась. Участок размером с софтбольный мячик стал цвета красного корвета и пульсировал, словно марширующий оркестр, играющий рэп. Я промыла ранку перекисью водорода и смазала её неоспорином. Думала, этого будет достаточно, чтобы с ней справиться… Инфекция в ранке начиналась типично. Припухлость, краснота, очень интенсивная боль… усиление боли. Затем образуются "волдыри", причём очень похожие на пузыри от ожогов, только более красные, и, верите или нет, гораздо болезненнее. Ещё более жуткая особенность этих вздутий в том, что они являются первым этапом процесса, развивающегося как гангрена. Ещё страшнее (или сравнительно хуже) то, что половине пациентов требуется некрэктомия (глубокое соскабливание тканей… а можете представить выскабливание области, которая к тому же страшно болит?), но чаще – ампутация… Центр по контролю и профилактике заболеваний успокоил меня: "Радуйтесь, что у вас хоть нога осталась"».
|

ПОПУЛЯРНОЕ ВЧЕРА ОБСУЖДАЮТ

МЫШЕЛОВКА ЗАХЛОПНУЛАСЬ? УЭК (БИОМЕТРИЧЕСКИЙ ПАСПОРТ) – ОКОНЧАТЕЛЬНОЕ ОТРЕЧЕНИЕ ОТ ХРИСТА, ДАЛЕЕ – ЗОМБИРОВАНИЕ И ПЕЧАТЬ
Главные новости / Публикации / Православие / Глобализация / Апостасия / Апокалипсис / Эл.концлагерь / УЭК | 20 августа 2012
0
1 115 541

ПОЗИТИВ. У каждого своя миссия...Тайган едет спасать животных Донбасса. (ВИДЕО)
Сегодня, 16:58
0
3 691

|
21 мая 2014
Просмотров: 9 305
|

Эти бактерии питаются нефтью - впрочем, и почти любой другой органикой тоже. Их клетки полностью искусственные, со сконструированным компьютером геномом, вообще не содержат какой-либо природной ДНК, зато содержат в себе особые цепочки «водяных знаков» с тем, чтобы геном опознавался как искусственный. Бактерия также обладает устойчивостью к антибиотикам.
Эти бактерии питаются нефтью - впрочем, и почти любой другой органикой тоже. Их клетки полностью искусственные, со сконструированным компьютером геномом, вообще не содержат какой-либо природной ДНК, зато содержат в себе особые цепочки «водяных знаков» с тем, чтобы геном опознавался как искусственный. Бактерия также обладает устойчивостью к антибиотикам.